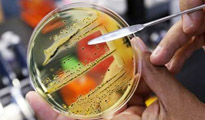

|
 |
|
|
New Delhi:
Government on Thursday expressed surprise at scientists in the
United Kingdom linking a new superbug resistant to antibiotics to
India and said that it was drafting a reply to an alert issued by
Britain in this regard.
The National Centre for Disease Control (NCDC), a nodal agency under
the Health Ministry, is meeting today and "we would soon draft a
reply to this," Secretary, Health Research, V M Katoch said.
He said the ministry will examine the issue in detail but it was
"unfortunate that this new bug, which is an environmental thing, has
been attached to a particular country which is India in this case".
"I am surprised," he said, adding that, "this (the bug) is present
in nature. It is a random event and cannot be transmitted".
Katoch said that he was surprised that a research paper linked it
with India as they should know it was a biological phenomenon.
According to a paper published in scientific journal 'Lancet, the
new superbug, which is said to be resistant even to most powerful
antibiotics, has entered UK hospitals and is travelling with
patients who had gone to countries like India and Pakistan for
surgical treatments.
Bacteria that make an enzyme called NDM-1 or New Delhi-Metallo-1,
have travelled back with NHS patients who went abroad to countries
like India and Pakistan for treatments such as cosmetic surgery, it
said.
Although there have only been about 50 cases identified in the UK so
far, scientists fear it will go global.
NDM-1 can exist inside different bacteria, like Ecoli, and it makes
them resistant to one of the most powerful groups of antibiotics -
carbapenems.
These are generally reserved for use in emergencies and to combat
hard-to-treat infections caused by other multi-resistant bacteria.
At least one of the NDM-1 infections the researchers analysed was
resistant to all known antibiotics.
Similar infections have been seen in the US, Canada, Australia and
the Netherlands and international researchers say that NDM-1 could
become a major global health problem. Infections have already been
passed from patient to patient in UK hospitals.
Dr David Livermore, one of the researchers and who works for the
UK's Health Protection Agency (HPA), said, "There have been a number
of small clusters within the UK, but far and away the greater number
of cases appear to be associated with travel and hospital treatment
in the Indian subcontinent".
The Department of Health has already put out an alert on the issue,
he said.
|